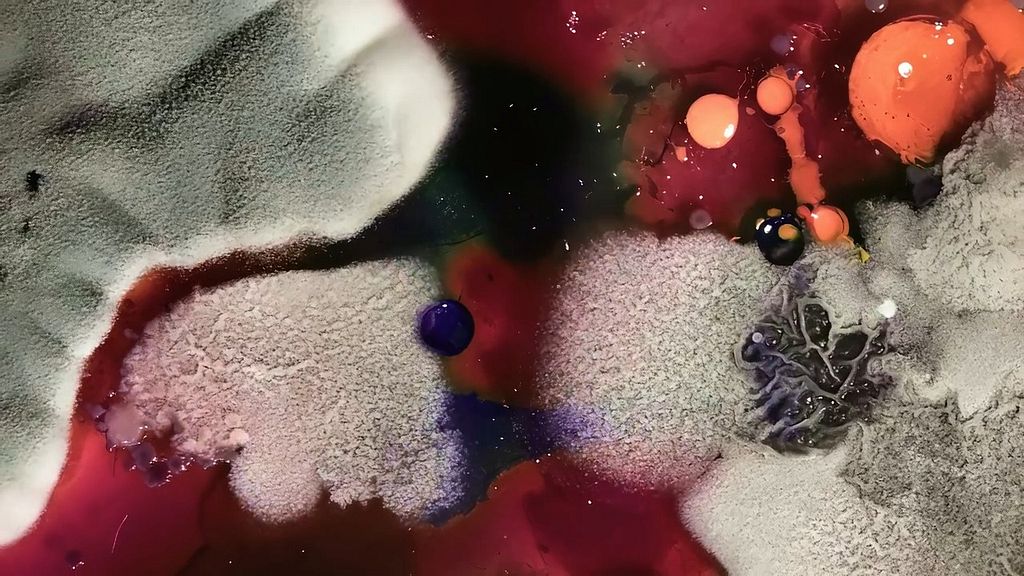

)
OFFF Barcelona announce full lineup and new formats
The world’s leading festival of art, design, and creativity will take place April 16-18 at Disseny Hub. OFFF Barcelona also reinforces its goal of opening the festival to the general public with initiatives such as The Screen and La Plaça Design Market.
Only one month remains until OFFF Barcelona, the most forward-thinking international festival in creativity, art, and digital design, once again brings together some of the most innovative and outstanding talents in the industry at Disseny Hub.
From April 16 to 18, the festival will celebrate its 26th edition with a lineup of 45 speakers who will present their creative processes firsthand, alongside workshops and masterclasses that bring the total number of participating creatives to 95.
This year’s visual campaign, Cultured, was created by Uncommon Creative Studio. A preview is already available, and the full hero film will be unveiled on the first day of the festival, presented by Nils Leonard, founder of the studio.
The diverse disciplines, experiences, and creative backgrounds that will converge at OFFF this year are joined by new formats and parallel activities that will turn Barcelona into the capital of creativity.
This edition will feature hands-on workshops led by creatives, as well as masterclasses from industry leaders such as Adobe, Maxon, Houdini.
In addition, OFFF introduces a new format this year: TIPS & TRICKS, small-audience sessions where six renowned speakers will share their experience. These will be close, informal conversations in which experts discuss topics such as career challenges, leadership, and professional reinvention, among others.
The Full Pass, which grants access to all three days of the festival, and Day Tickets are now available on the festival website.
Tickets for the closing day on April 18 will also be available soon. This event will include the final talk by Silent Partners Studio, an audiovisual show by Hamill Industries, and a mapping projection on the façade of Disseny Hub.
For those who want to continue the celebration, tickets are already available for the Afterparty on April 18 at La Paloma, featuring DJ sets by San Jones, Nahoomie, and Drea.
Credits
powered byNew confirmations for the festival
With one month to go before the festival begins, OFFF Barcelona has announced new speakers who will take part at Disseny Hub. Among the latest confirmations are global references in creativity and visual innovation such as teamLab, the Japanese collective renowned for its immersive digital installations, and Moment Factory, a pioneering studio in large-scale multimedia experiences and audiovisual environments whose clients include Real Madrid and Madonna. Also joining the lineup is Wieden+Kennedy Amsterdam, named Global Agency of the Year 2025 by Adweek.
The program is further strengthened by leading studios and agencies in design, branding, and motion such as FutureDeluxe, Uncommon, Hamill Industries, and Base Design, who will share their perspectives on the processes and trends shaping contemporary creativity.
The festival also welcomes creators who expand the boundaries between disciplines, including James Beacham, a physicist and artist exploring the relationship between science, technology, and art, and Johanna Jaskowska, a digital artist known for her pioneering work in virtual aesthetics, digital identity, and online culture.
In addition, the festival will feature two special panels led by Creative Review and Stash, two of the most influential international media platforms in the creative industry. With these new confirmations, OFFF Barcelona continues to strengthen a program that brings together some of the most relevant figures and studios in the global creative landscape.
A festival open to the city
OFFF continues its commitment to the city of Barcelona by presenting different initiatives designed to turn the city into a home for creativity. The aim is to bring the talent of some of the most curious and innovative minds closer to the public and to create a unique and enriching cultural experience.
Once again, one of the highlights of the festival program is The Screen, a mapping experience projected onto the façade of Disseny Hub, free and open to the public during the three nights of the festival, with a different program each evening. The showcase originates from an open call that received more than 730 submissions (compared with 350 last year) from 63 countries across five continents. On March 19, the selected projects that will be projected for audiences gathering at Disseny Hub will be announced.
The Screen will also feature works commissioned directly by the festival. PJ Richardson, Burton Rast, Caserne, Somnia Lab, Onionlab, and Framemov will create pieces specifically for this mapping experience.
In addition, Uncommon will produce a special piece for the mapping as part of the festival’s visual campaign.
This year, the closing event and one of the festival’s highlights, the Main Titles, will take place outdoors for the first time, specifically on the façade of Disseny Hub. PJ Richardson, an American creative director, has been commissioned to design this year’s Main Titles, which celebrate “the idea that the festival is made by everyone who attends it: a collective of creatives who come together to learn, find inspiration, and celebrate design.”
Another activity open to the public during these days is La Plaça Design Market. This traditional market once again presents a curated selection of 15 local and international design projects, offering a diverse range of creative products such as books, clothing, accessories, and more. It serves as an essential meeting point for design enthusiasts who want to discover unique pieces, connect with designers, and experience the best of both local and international creativity.
The future of design at NXT
OFFF offers a comprehensive view of the present in art, design, and creativity, but also looks toward the future. For this purpose, the festival presents NXT for the third consecutive year, a platform dedicated to showcasing the next generation of emerging talent.
At this exhibition, visitors can explore innovative projects and experience firsthand presentations led by students from 10 of the leading creativity and design schools: AMD, BAU, Brother, CTIM-UPC, Elisava, IDEP, IED, Labasad, LCI, and Université de Franche-Comté. Through student-led presentations, NXT provides young creatives the opportunity to showcase their projects to a global audience and begin making their mark in the professional design world.
)